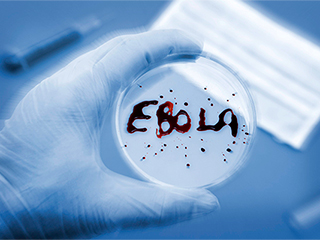
Российские врачи спасут больных Эболой Российские врачи спасут больных Эболой

10 октября, четверг | ![]() ![]() ![]() |
![]() | ПОЛИТИКА | ЭКОНОМИКА | ОБЩЕСТВО | ПРОИСШЕСТВИЯ | КУЛЬТУРА | СПОРТ | МЕДИА | В МИРЕ | АВТО | ТЕХНОЛОГИИ | ![]() |
| Фоторепортажи | Видеосюжеты | Комментарии | Погода | Работа | Форум | Карта | Подписка и RSS | Реклама| О газете |
Российские врачи спасут больных Эболой21 августа 2014, четверг, 12:59 – БРЯНСК.RU | Комментарии: 0
| Версия для печати Роспотребнадзор совместно с МЧС направляют в Гвинейскую республику группу врачей с мобильной лабораторией. В составе российской бригады – эпидемиологи, вирусологи и бактериологи.Российский спецборт, предоставленный МЧС России, доставит в Гвинею, где бушует страшная лихорадка Эбола, российскую противоэпидемическую бригаду. "МЧС России направляет в республику Гвинея спецборт Ил-76 с мобильной лабораторией и специализированной противоэпидемической бригадой на борту",– сообщает представитель Управления информации министерства. "В связи с напряженной эпидемиологической обстановкой по лихорадке Эбола в странах Западной Африки и на основании официального запроса от Республики Гвинея в адрес правительства Российской Федерации Роспотребнадзор подготовил к отправке в город Конакри мобильный комплекс специализированной противоэпидемической бригады", – цитирует ИТАР-ТАСС представителя Роспотребнадзора. Вылет российского спасательного самолета запланирован на вечер 21 августа с подмосковного аэродрома Раменское. Передвижная российская лаборатория оснащена современным оборудованием для диагностики лихорадки Эбола и других опасных инфекционных заболеваний. В составе бригады специалистов, направляющихся в Гвинею, эпидемиологи, вирусологи и бактериологи. Напомним, что заболевания лихорадкой Эбола установлены в Либерии, Сьерра-Леоне, Гвинее и Нигерии. Число погибших в Западной Африке превысило тысячу человек. Геморрагическая лихорадка – смертельная болезнь, которая может распространяться через прямой незащищенный контакт с кровью или выделениями инфицированного человека, а также в результате контактов с предметами, которые были загрязнены от зараженного. Ранее Соединенные Штаты тоже оказали помощь странам, пострадавшим от страшного вируса. Американцы доставили в Либерию партию экспериментальной вакцины ZMapp от лихорадки Эбола. По данным Всемирной организации здравоохранения, всего существует не более 10-12 доз. Источник:
|
![]() | ПОЛИТИКА | ЭКОНОМИКА | ОБЩЕСТВО | ПРОИСШЕСТВИЯ | КУЛЬТУРА | СПОРТ | МЕДИА | В МИРЕ | АВТО | ТЕХНОЛОГИИ | ![]() |
| Фоторепортажи | Видеосюжеты | Комментарии | Погода | Работа | Форум | Карта | Подписка и RSS | Реклама| О газете |
| Размещение рекламы в газете БРЯНСК.RU: Прайс-лист, тел. (4832) 37-19-38, почта info@briansk.ru Для информационных писем в редакцию: news@briansk.ru | ![]() | ![]() | ||
| 2005–2015 © Ежедневная интернет-газета БРЯНСК.RU При цитировании активная ссылка на БРЯНСК.RU обязательна Материалы газеты могут содержать информацию 18+ | ![]() | Открыв данный сайт, Вы соглашаетесь с Правилами cайта (договор-оферта). Если вы не согласны с Правилами, немедленно покиньте сайт! | ![]() |

В глубине экрана: Мастер-класс по ремонту телевизоров
Погружение в мир футбола онлайн: для поклонников Игры
Займ без проверок
Тотализаторы: что это такое и чем они отличаются от обычных ставок?
Играть в бесплатные игровые автоматы в онлайн-клубе Вулкан
Стоит ли посещать офтальмолога при замене очков?
Успешные игроки предпочитают игровые автоматы Вулкан
Новое казино Супер Слотс поможет воплотить ваши мечты в реальность







ПОПУЛЯРНЫЕ МАТЕРИАЛЫ










